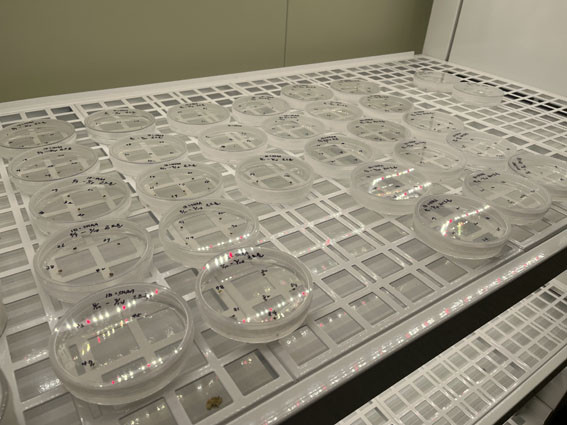

|
|

|
|
ÇÁ¸®Áö¾Æ ¹«º´ ¿ì·®¹¦ º¸±Þ ¹ßÆÇ ¸¶·Ã
|
|
°ñµå¹®¡¤ÈÀÌÆ®¹® ¹ÙÀÌ·¯½º ¹«º´ ¿ì·®¹¦ Á¶Á÷¹è¾ç ±â¼ú È®¸³ ¡®¹ÚÂ÷¡¯
|
|
2023³â 11¿ù 08ÀÏ(¼ö) 10:17 [(ÁÖ)¿Â¾ç½Å¹®»ç] 
|
|
|
|
| | ¡è¡è ¡ãÇÁ¸®Áö¾Æ ¹«º´¹¦ Á¶Á÷¹è¾ç °úÁ¤ <»çÁøÁ¦°ø=Ãæ³²µµ³ó¾÷±â¼ú¿ø> | ¨Ï ¿Â¾ç½Å¹® | | Ãæ³²µµ ³ó¾÷±â¼ú¿øÀº ÇÁ¸®Áö¾ÆÀÇ Ç°Áú Çâ»ó ¹× ¼ö·® Áõ´ë¸¦ À§ÇÑ ¹ÙÀÌ·¯½º ¹«º´ ¿ì·®¹¦ º¸±ÞÀ» À§ÇØ ±¸±Ù ¹è¾çÀ» ÅëÇÑ Á¶Á÷¹è¾ç¹¦ À°¼ºÀ» ÃßÁø ÁßÀ̶ó°í 11¿ù 8ÀÏ ¹àÇû´Ù.
ÇÁ¸®Áö¾Æ´Â ±¸±Ù¹ø½Ä ÀÛ¹°·Î ¹ÙÀÌ·¯½º¿¡ °¨¿°µÇ¸é ÀÙ¿¡ ¿¬ÇÑ È²»öÀÇ ¸ðÀÚÀÌÅ© ¹«´Ì°¡ ³ªÅ¸³ª¸ç, ½ÉÇÏ¸é ¿¬ÇÑ ³ì»ö ºÎºÐÀÌ ±«»çÇØ »óǰ¼º°ú »ý»ê·®À» °¨¼Ò½ÃÄÑ ³ó°¡ ¼Òµæ¿¡ Å« ÇÇÇØ¸¦ ÁØ´Ù.
Á¶Á÷¹è¾ç¹¦´Â ¹è¾ç½Ç¿¡¼ ¹ÙÀÌ·¯½º°¡ ¾ø´Â »ýÀåÁ¡À» äÃëÇØ ¹è¾çÇÑ ÈÄ Áõ½Ä¡¤¼øÈ °úÁ¤À» °ÅÃÄ »ý»êÇϸç, ÀϹݹ¦¿¡ ºñÇØ ¾à 30% Á¤µµ ¼ö·® Áõ´ë°¡ °¡´ÉÇÏ´Ù.
Á¤¼ÛÀÌ µµ ³ó¾÷±â¼ú¿ø ¿ø¿¹¿¬±¸°ú ¿¬±¸»ç´Â ¡°¾ÕÀ¸·Î Á¶Á÷¹è¾ç ±â¼úÀ» ÀÌ¿ëÇÑ ÇÁ¸®Áö¾Æ °ÇÀü ¿ì·®¹¦ À°¼º ¿¬±¸¸¦ Áö¼ÓÇØ ¹«º´ ¿ì·®¹¦ À°¼ºÀ» À§ÇÑ Áõ½Ä ¹× ¹ß±Ù ¹è¾ç Á¶°ÇÀ» È®¸³ÇÏ°í ³ó°¡ÀÇ ¾ÈÁ¤ÀûÀÎ ±¸±Ù »ý»êÀ» µµ¿ï °Í¡±À̶ó°í ¸»Çß´Ù.
|
|
|
|
¿Â¾ç½Å¹®»ç ±âÀÚ ionyang@hanmail.net ¡°Áö¿ªÁ¤½Å ¿Â¾ç½Å¹®¡± - Copyrights ¨Ï(ÁÖ)¿Â¾ç½Å¹®»ç.
¹«´Ü ÀüÀç ¹× Àç¹èÆ÷ ±ÝÁö -
|
|
|
|
(ÁÖ)¿Â¾ç½Å¹®»ç
±â»ç¸ñ·Ï | ±â»çÁ¦°ø : (ÁÖ)¿Â¾ç½Å¹®»ç
|
|
|
|
|
|
|
|
|
|
|
|

|
|
|
|
ÃÖ±Ù±â»ç
|
|
|
|
|
½Ã¼³°ü¸®°ø´Ü, Â÷º° ¾øÀÌ ÀÌ¿ëÇÒ ..
|
|
½Ã¼³°ü¸®°ø´Ü, ¾ÈÀü ÀÇ½Ä °íÃë ¹×..
|
|
À̸í¼ö ¿¹ºñÈĺ¸, Ãæ³²±³À°ÇöÀå ..
|
|
¾Æ»ê°í, ¶ß°Å¿î °ü½É ¼Ó¿¡ ÁøÇÐ ..
|
|
À̱â¾Ö¡¤ÀÌÀ±±¸¡¤À±¿øÁØ¡¤Àü³²¼ö..
|
|
Ãæ³²¾Æ»ê, â´Ü ù ½ºÆä¼È À¯´ÏÆû..
|
|
2026³â Àå¾ÖÀÎÀÇ ³¯ ¸Â¾Æ ¹ß´ÞÀå..
|
|
NH³óÇùÀºÇà ¾Æ»ê½ÃÁöºÎ, ÇϳªÀºÇà..
|
|
¾Æ»ê½Ã³ë»ç¹ÎÁ¤ÇùÀÇȸ, Áö¿ª°æÁ¦ ..
|
|
´ë¸¸ ¿©Çà¾÷°è, Ãæ³²°ü±¤ ¸Å·Â ü..
|
|
Çѱ¹À¯±³¹®ÈÁøÈï¿ø,ÀϺ» ŸÄí¼º..
|
|
°íÀ¯°¡ ÇÇÇØÁö¿ø±Ý ¡®±¹¹Îºñ¼ ¾Ë..
|
|
2027 ÃæÃ» U´ëȸ, ¼¼°è ¹«´ë ÇâÇÑ..
|
|
Èû½ë Ãæ³², Áßµ¿ Àå±âÈ Á¾ÇÕ´ëÃ¥..
|
|
¾Æ»êÆú¸®ÅØ´ëÇÐ, °ø°ø ¾ÈÀü ºÐ¾ß ..
|
|
Ãæ³²½Ã°¢Àå¾ÖÀκ¹Áö°ü, Á¦12ȸ Æò..
|
|
°¡Á·°ú ÀÌ¿ôÀ» ÁöÄÑÁÖ´Â ¾ÈÀüÀåÄ¡
|
|
Ãæ³²±³À°Ã», Á¦46ȸ Àå¾ÖÀÎÀÇ ³¯ ..
|
|
Ãæ³²°úÇб³À°¿ø ¸¶¼ú´Ü, ù ½Ãµ¿
|
|
¡®2026 °úÇÐÃàÁ¦¡¯ ¼ºÈ²¡¦¾à 5õ..
|
|
|